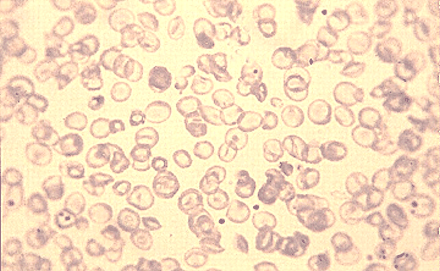

ما الفرق بين الانيميا المنجلية وانيميا البحر المتوسط؟
معلومات الإستشارة
معلومات الطفل
معلومات إضافية
نص الإستشارة
ما الفرق بين الانيميا المنجلية وانيميا البحر المتوسط؟ الفرق بين سيكل سل و ثلاسيميا , الفروق بين مرض الثلاسيميا و مرض السيكل سل
رد الطبيب
ما الفرق بين الانيميا المنجلية وانيميا البحر المتوسط؟
السلام عليكم
الفرق بين الانيميا المنجلية وانيميا البحر المتوسط (أو الثلاسيميا ) هو كما يلي :
مرض الخلايا المنجلية والثلاسيميا هي اضطرابات وراثية ناتجة عن أخطاء في جينات الهيموجلوبين ، وهي مادة تتكون من بروتين ("غلوبين") بالإضافة إلى جزيء الحديد ("الهيم") المسؤول عن حمل الأكسجين داخل خلايا الدم الحمراء.
يمكن أن تسبب هذه الاضطرابات التعب واليرقان ونوبات من الألم تتراوح من خفيفة إلى شديدة للغاية.
و هي أمراض وراثية ، وعادة ما يجب على كلا الوالدين نقل جين غير طبيعي حتى يصاب الطفل بالمرض.
عندما يحدث هذا ، قد تكون الأمراض الناتجة خطيرة وفي بعض الأحيان مميتة.
داء الكريات المنجلية :

تم اكتشاف مرض فقر الدم المنجلي لأول مرة في أوائل القرن العشرين ، وقد وُصِف بأنه "كريات الدم الحمراء المنجلية الغريبة الشكل [خلايا الدم الحمراء مثل الهلال او المنجل]".
مع مزيد من الدراسة ، اقترح أخصائي علم الأمراض الشهير في وقت لاحق أن الألم الذي يعاني منه مرضى الخلايا المنجلية ناتج عن انسداد الأوعية الدموية الدقيقة.
في دراسة تاريخية عام 1949 ، خلص الدكتور لينوس بولينج إلى أن مرض فقر الدم المنجلي ناتج عن الهيموجلوبين غير الطبيعي ، والمشار إليه باسم "الهيموجلوبين S."
كان المرض من بين أول الأمراض التي تم فهمها تمامًا على المستوى البيوكيميائي ، حيث تعلم الباحثون أن الهيموجلوبين غير الطبيعي كان في الواقع يتغير شكله (يسمى "المنجل") بسبب خطأ واحد في الأحماض الأمينية في الهيموجلوبين S.
على الرغم من أن السبب الجزيئي الكامن وراء المرض قد تم فهمه منذ أكثر من نصف قرن ، إلا أن التقدم في ترجمة هذه المعرفة إلى رعاية أفضل للمرضى كان بطيئًا. يعكس هذا جزئيًا الصعوبة الجوهرية في علاج المرض.
مع تحسن التقدم العلمي والتكنولوجيا ، تطورت أنظمة علاج جديدة لمرضى فقر الدم المنجلي.
وجدت دراسة البنسلين الوقائية (PROPS) أن إعطاء البنسلين ، وهو مضاد حيوي ، عندما لا يكون المرضى مرضى يمكن أن يمنع الموت المرتبط بالعدوى الخطيرة في مرض فقر الدم المنجلي.
في وقت لاحق ، أظهرت دراسة زرع نخاع العظام متعددة المراكز أن 84 في المائة من الأطفال المصابين بمرض فقر الدم المنجلي والذين تلقوا عملية زرع نخاع عظمي من قريب لهم يمكن علاجهم.
أخيرًا ، في منتصف التسعينيات ، وافقت إدارة الغذاء والدواء الأمريكية على علاج جديد يسمى هيدروكسي يوريا كعلاج لتقليل مضاعفات المرض.
يعمل هيدروكسي يوريا جزئيًا عن طريق تحفيز الجسم لاستئناف إنتاج الهيموغلوبين الجنيني (الهيموغلوبين F) ، وهو الهيموغلوبين الطبيعي في الجنين الذي يمنع المنجل.
في العقد الماضي ، تم إحراز مزيد من التقدم في أبحاث الخلايا المنجلية.
قام الباحثون بتحسين برامج العيادات الخارجية للسيطرة على الألم ، وحددوا ارتفاع ضغط الدم الرئوي باعتباره أحد المضاعفات الشائعة التي تهدد الحياة لمرض الخلايا المنجلية ، وطوّروا طرقًا جديدة لتحديد عوامل الخطر الجينية لمضاعفات المرض الأخرى.
الثلاسيميا أو انيميا البحر المتوسط :
تم وصف الثلاسيميا ، أو فقر الدم في البحر الأبيض المتوسط ، لأول مرة في عام 1925 من قبل طبيب في ديترويت درس الأطفال الإيطاليين المصابين بفقر الدم الحاد (مستويات منخفضة من خلايا الدم الحمراء) ، وضعف النمو ، وأعضاء البطن الضخمة ، وموت الأطفال المبكر.
في عام 1946 ، وجد أن سبب مرض الثلاسيميا هو بنية غير طبيعية للهيموجلوبين.
يتفاعل الجسم عن طريق تخرب خلايا الدم الحمراء مبكراً، مما يسبب فقر الدم.
للتعويض عن الخسارة ، يحاول الجسم إنتاج خلايا الدم الحمراء بسرعة أكبر ، مما يتسبب في مضاعفات الثلاسيميا الأخرى ، مثل تشوهات العظام وتضخم الطحال.
في الستينيات ، بدأ الأطباء الذين يعالجون مرضى الثلاسيميا بنقلهم بخلايا دم حمراء جديدة كل شهر.
خفف هذا من معظم أعراض الطفولة وأدى إلى تحسن كبير في البقاء على قيد الحياة.
لا يزال نقل الدم يستخدم كعلاج حتى اليوم.
ومع ذلك ، نظرًا لأن الدم يحتوي على كميات كبيرة من الحديد ، والتي لا يستطيع الجسم التخلص منها بشكل طبيعي ، فإن معظم المرضى يموتون في سنوات المراهقة من التلف الناجم عن الكثير من الحديد.
وجد الباحثون في وقت لاحق أنه يمكن إزالة الحديد الزائد من الجسم عن طريق العلاج بعقار يسمى ديفيروكسامين.
منع هذا الدواء أمراض القلب التي يسببها الحديد وساعد المرضى على العيش لفترة أطول.
في الآونة الأخيرة ، يتوفر نوعان من الأدوية عن طريق الفم لإزالة الحديد.
لقد قاموا بتحسين نوعية حياة المرضى الذين يعانون من فرط الحديد من عمليات نقل الدم للثلاسيميا بشكل كبير.
علاوة على ذلك ، يمكن أن تجد اختبارات التصوير المتخصصة الآن الحديد في القلب وتسمح للمرضى بالعلاج قبل أن يصابوا بفشل القلب المرتبط بتراكم الحديد.
كما هو الحال مع مرض فقر الدم المنجلي ، يمكن للأدوية التي تزيد من إنتاج الهيموجلوبين الجنيني أن تصحح جزئيًا فقر الدم الناتج عن مرض الثلاسيميا ، لكن الجهود المبذولة لتحسين علاج الثلاسيميا مستمرة.
الاتجاهات المستقبلية :
الأدوية التي تزيد من نسبة الهيموجلوبين الجنيني في كل من مرض فقر الدم المنجلي والثلاسيميا قد حسنت بشكل كبير حياة المرضى الذين يعانون من هذه الأمراض ؛ ومع ذلك ، لا يزال يتم البحث عن أدوية أكثر أمانًا وفعالية.
يمكن استخدام زرع الخلايا الجذعية لعلاج كلا المرضين ، ولكن لها العديد من القيود.
من الضروري إجراء مزيد من البحث لتحسين سلامة الزرع ، خاصة عند استخدام الخلايا الجذعية من متبرعين غير مرتبطين ، قبل أن يتم قبولها على نطاق واسع كعلاج آمن وفعال.
أخيرًا ، فإن الأمل طويل الأمد في علاج كلا هذين المرضين بنجاح هو تصحيح الخطأ في جين الغلوبين نفسه. في حين أنه من الممكن إجراء هذا النوع من العلاج الجيني على الحيوانات ، إلا أن هناك العديد من العقبات التي يجب التغلب عليها قبل أن تنجح التجارب البشرية.